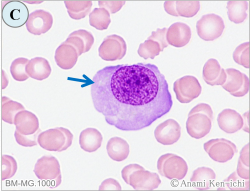

皆さま、明けましておめでとうございます。本年もマンスリー形態マガジンをどうぞよろしくお願い申し上げます。
2026年の幕開けにあたり、日本の伝統工芸の一つをご紹介したいと思います。福井県越前市は、約1500年の歴史を持つ和紙の産地として知られ、その丈夫さと美しさは、奈良の正倉院に現存する品々からもうかがうことができます。越前市にある「紙の文化博物館」では多くの和紙が展示されており、その一角で「越前墨流し(えちぜんすみながし)」を見ることができます。
越前墨流しとは、日本で最も伝統的な技法で作られる墨流しで、その始まりは平安時代とされています。広場治左衛門が良質な水を求めて越前に辿り着き、この技法をもって墨流しを発展させたといわれています。その伝統技法を継承した福井在住の福田忠雄さんは、墨流しの巨匠とも称され、2000年には福井県の無形文化財技術保持者に認定されています。
墨流しの技法は、桶に地下水を張り、墨(絵の具)の筆と松脂の筆を交互につけて同心円を描き、次に息を吹きかけたり扇子で風を送ったりして同心円を崩しながら模様を作ります。模様ができたら、和紙を中心から静かに乗せ、紙全体を水面に置きます。水面に広がる染料が織りなす偶発的な模様を和紙に吸い取らせ転写します。墨の濃淡や異なる染料を組み合わせることで、さまざまなパターンや雰囲気を生み出すことができます。
その墨流しを京友禅染めに応用したのが、京都を拠点とする薗部正典さんです。この方も2017年に黄綬褒章を授与され、墨流し染めの第一人者として技術革新を続けるとともに、後進の育成にも尽力されています。唯一無二の芸術性の高い一点物として、伝統を重んじつつ現代的なセンスを大切にしたい方にとって、満足度の高い着物といえるのではないでしょうか。


2025年12月号の問題. 下記のご質問をいただきましたがどのようにお答えしますか。
| 【Q1】 | ヒトパルボウイルスB19感染に出現する前赤芽球の形態は正常の前赤芽球と同じでしょうか、また赤芽球癆に関して形態情報を教えてください。 | |
| 【助言1】 | ヒトパルボウイルスB19の感染により、本ウイルスは赤芽球系前駆細胞に選択的感染し、成熟の障害や破壊をもたらすことから、骨髄中の赤芽球は消失し、残存する前赤芽球には親和性を示すことで巨大化となり巨大前赤芽球の形態を呈することが特徴です。 本ウイルスの感染は急性赤芽球癆とされ、胸腺腫などが原因で起こる慢性赤芽球癆がありますが、こちらは骨髄の赤芽球の消失はみられても巨大前赤芽球が出現することはありません。双方と赤血球系のみの異常で貧血が起こりますが一過性とされます。 |
|
| 【Q2】 | 標的赤血球は、肝疾患やサラセミアで出現するといわれますが、その出現機序は異なるのでしょうか。。 | |
| 【助言2】 | 標的赤血球は、赤血球の表面積/体積比が増加する病態で出現します。慢性肝疾患では、脂質代謝異常により、赤血球膜の遊離コレステロールやリン脂質が挿入すると膜過剰が生じ表面積が物理的に拡大し増加することで出現します。一方、サラセミアでは、グロビン鎖の合成障害により、細胞内のヘモグロビン量が減少し、体積が小さくなるために相対的に表面積が拡大することで標的に変形するとされます。 | |

2026年1月号の問題. 下記のご質問をいただきましたがどのようにお答えしますか。
| 【Q1】 | 鉄染色で陽性の顆粒が微細であっても、核周1/3以上かつ5個以上あれば環状鉄芽球と判定してもよいですか。鉄染色をうまく染めるコツをお願いします。 |
|
| 【Q2】 | 赤芽球系前駆細胞あたりに発生する異常とそれに関連する血液疾患を教えてください。 |
|

形態マガジン号キャプテン 阿南 建一

「細胞同定」は、末梢血におけるMG染色の細胞同定と骨髄における特殊染色の所見から細胞を判読することに挑戦します。
「ワンポイントアドバイス」は、ヒトパルボウイルスB19感染による前赤芽球の形態と標的赤血球の出現機序について解説します。
なお、2月号から「探しもの」と題し新コーナーが始まりますのでご期待ください。
1. 細胞同定
BM-MG.1000

BM-MG.1000

BM-MG.1000
BM-MG.1000

問題
骨髄像の細胞同定を行ってください。
【解説】

A-1. 直径10μm大、核は円形でN/Cは高く、クロマチンは粗剛で凝集塊状、細胞質は多染性(青紫色)のことから多染性赤芽球にしました。
A-2. 直径17μm大、核は分葉しクロマチンの結節は軽度、細胞質は二次顆粒を認めることから分葉核球になりますが、正常に比し大型であることで変性傾向にあるものと思います。
A-3. 直径14µm大、核は円形で偏在しクロマチンは粗造、細胞質は二次顆粒とみなし骨髄球にしました。
A-4. 直径9μm大、核は円形でクロマチンは凝集塊状、細胞質は薄めながら多染性(青紫色)のことから多染性赤芽球にしました。
A-5. 直径12µm大、核は分葉しクロマチンは結節状、顆粒は細かく二次顆粒とみなし分葉核好中球にしました。

B-1. 直径18μm大、核は類円形で偏在しクロマチンは顆粒状、細胞質は好塩基性で顆粒は粗大で一次顆粒とみなし前骨髄球にしました。
B-2. 直径10μm大、核は逸脱し細胞質のみが残存したものと判断しアーチファクトとしました。血小板に類似していますが、血小板は一般に中心部が顆粒質で辺縁部が硝子質で透明にみえることで異なります。
B-3. 直径15μm大、核はくびれクロマチンの結節は強くありませんが、顆粒は細かく二次顆粒とみなし分葉核球にしました。

C. 直径22μm大、大型で、核は円形で偏在しクロマチンの凝集は認めずスポンジ様の空隙を認め、細胞質は多染性(青紫色)のことから多染性巨赤芽球にしました。

D-1.2. 直径17μm大、細胞質の色調は正染性(橙紅色)であり、核の成熟障害(巨大化・不完全濃縮)を認めることから正染性巨赤芽球にしました。
D-3. 直径14µm大、N/Cは高く、核は円形でクロマチンは微細顆粒状、細胞質は好塩基性で辺縁に蕾状の突起を有することから小型の巨核芽球としました。
D-4. 直径28μm大、核は類円形でクロマチンは繊細顆粒状、細胞質は好塩基性が強く水泡状の突起を有し、正常の前赤芽球に比べるとクロマチンが繊細であることや大型であることから前巨赤芽球にしました。
これから先のページでは、医療関係者の方々を対象に医療機器・体外診断薬等の製品に関する情報を提供しております。当社製品を適正に使用していただくことを目的としており、一部の情報では専門的な用語を使用しております。
一般の方への情報提供を目的としたものではありませんので、ご了承ください。
医療関係者の方は、次のページへお進みください。
(お手数ですが、「進む」ボタンのクリックをお願いします)